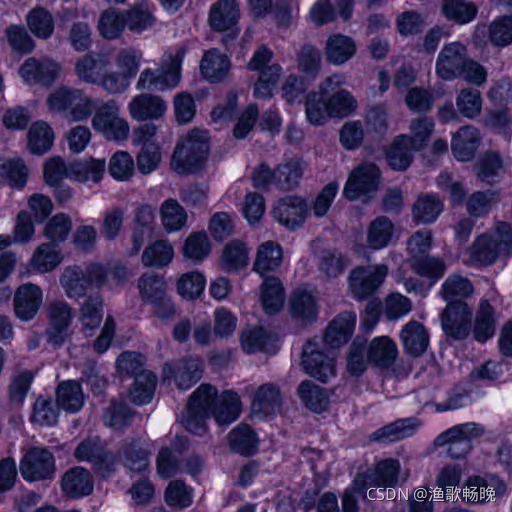

论文解读《BiX-NAS:医学图像分割的高效双向搜索架构》
文章发表出处:MICCAI2021(国际医学图像计算和计算机辅助干预协会(Medical Image Computing and Computer Assisted Intervention Society) 举办,跨医学影像计算(MIC)和计算机辅助介入 (CAI) 两个领域的综合性学术会议,是该领域的顶级会议)
项目网页(含代码以及论文):https://bionets.github.io/
论文:论文地址
代码:代码地址
摘要:最近,可循环的U-Net网络用在各种医学图像分割任务中。重用构建块来实现网络循环,不增加参数同时提升网络性能。
本文提出了一种高效的NAS方法,搜索出了超轻量的分割模型,在保证准确率的情况下大大节约了计算成本。
本文研究了双向跳跃连接 (bi-directional skip connection) 网络的多尺度(multi-scale) 变形,提出一种两阶段式神经结构搜索 (NAS) 算法BiX-NAS。轻量且有效的可循环结构。
一、引言:
基于深度学习的方法在医学图像分析中占有优势。U-Net是一种广泛使用的分段网络,它通过构建前向跳过连接(skip connections)来将编码器中的编码特征与解码特征聚合在一起。利用可重用构建块,对此类体系结构进行迭代推理,取得了最新进展。提出了一个递归U-Net,它在每次迭代时递归成对编码和解码块的子集。BiO-Net引入了反向跳过,将解码器中的语义传递到同一级别的编码器。虽然这种反复的设计可以大大缩小网络的规模,按照预先设定的运行时间,计算成本仍不可避免地增加。
同时,多尺度方法的成功表明,可以使用融合细粒度特征和粗粒度语义的多尺度跳过。为此,引入多个语义尺度的前向/后向跳转,以较低的计算成本搜索多尺度特征的有效聚合是一个非常重要的研究方向。
在本文中,提出了一种有效的多尺度(抽象为“X”)NAS方法,即BiX-NAS,它通过不断跳过多尺度特征,同时丢弃不重要的特征来搜索最优的双向结构(BiX-Net)。
本文的研究成果主要体现在以下三个方面:
(1)以双向循环的方式研究了多尺度融合方案,提出了一种有效的两阶段神经网络体系结构搜索(NAS)策略,即BiX-NAS,该策略可自动搜索最优的双向体系结构。
(2)分析了经典进化搜索算法搜索缺陷的瓶颈,提出了一种新的渐进式进化算法,加快搜索过程。
(3)我们的方法以三个医学图像分割数据集为基准,并在相当大的范围内超过了其他先进的算法。
二、方法简介:
(1)引入多尺度跳跃连接的有效性网络BiO-Net
(2)演示了BiX-NAS每个阶段的细节
(3)提出了跳跃公平性原则,以确保搜索公平性和效率。

图1所示。BiO-Net、BiO-Net++和BiX-Net的概述,具有4级和2次迭代。同一级别的编码器和解码器块被重复利用。
1.BiO-Net++ 轻量的BiO-Net多尺度升级版
如何轻量化模型是一个非常重要的问题。在一个前序工作中,BiO-Net会触发多个编码(encoding) 和解码 (decoding) 阶段,将同一尺度的特征用双向跳跃连接融合起来(上图左)。会根据迭代次数,增加计算成本。
本文首先依据BiO-Net,提出了BiO-Net++(图1中)。注意,特征融合策略由(连接)concatnation优化为element-wise (同位元素对应相乘)。
(1) 作为提取阶段的连续编码或解码过程。在提取过程,有四个提取阶段,有两次迭代。(with 4 levels and 2 iterations)。
(2) 为了融合多尺度特征,通过双向跳过紧密连接到每个解码/编码层次。采用 双线性调整(Bilinear adjustment) 调整不同层次上不一致的空间维度。
element-wise:对应元素逐个相乘
虽然多尺度特征融合并缩小了网络规模,但仅在整体性能方面带来微小改善(下表1)。本文目标寻找一种更稀疏连接的BiO-Net++子结构,可以减轻计算负担。

DICE: 对于分割过程中的评价标准主要采用Dice相似系数(Dice Similariy Coefficient,DSC),Dice系数是一种集合相似度度量指标,通常用于计算两个样本的相似度,值的范围 0~1,分割结果最好时值为 1 ,最差时值为 0。
2.BiX-NAS:超高效搜索BiO-Net++子结构
为此,本文提出了一种两阶段式搜索算法BiX-NAS,以找到稀疏连接的子结构。
(1) 阶段一中,其采用了一种可训练的选择矩阵(selection matrix)来缩小整体的搜索空间,
(2) 阶段二中引入进化 NAS (神经网络结构搜索) 来逐步进化出最佳的子结构。
神经结构搜索(Neural Architecture Search,简称NAS):是一种自动设计神经网络的技术,可以通过算法根据样本集自动设计出高性能的网络结构,在某些任务上甚至可以媲美人类专家的水准,甚至发现某些人类之前未曾提出的网络结构,这可以有效的降低神经网络的使用和实现成本。即是在此巨大的搜索空间里自动地找到最优的网络结构,实现深度学习的自动化。 (Differentiable NAS Research)可微分方法将搜索空间松弛化使其变成连续的,则可以使用梯度的方法来解决。 即将神经网络的结构也作为参数来进行梯度下降优化,给结构的选择以科学的方式。
2.1. Phase1(第一阶段):通过(选择矩阵)selection matrix缩小搜索空间
降低整体搜索难度,本文采用可微分NAS算法来快速筛掉那些易于发现的无效跳跃连接。
原理 是在每个搜索块中从N个进入的跳过连接中确定k个候选跳过连接,减少无效跳过连接。因此,对于有L层和T次迭代的BiO-Net++ 来说, 搜索空间大概是:

注意:NAS里面的一个重要问题是:待搜索的参数不可导。通过将问题简化后,提出了一种“可导”的解决方案,直接通过梯度下降算法来训练,即可得出结果。
控制网络结构的参数,一般是离散的。 例如:或者有一个分支网络,或者没有该分支网络,不存在有0.2个分支网络这样的情况。离散的一个特点是不方便求导。通过将搜索空间从离散放宽到连续,不使用之前在离散空间搜索的方式,而使用在连续空间内通过梯度下降来找到最优结果。
通过构建一个可学习的(选择矩阵)selection matrix M来对N个传入连接和k个候选连接之间的映射进行建模,并化为以下完全可微的方程:

class Block(Module):#定义模块
"""
Phase1 block
:skip: all N incoming skips
:alpha: a selection matrix with shape N*(N-2)#定义在跳跃连接中的选择矩阵
"""
def __init__(self, in_channel, out_channel, conv=None, batch_norm_momentum=0.01, last_decoder=False):
super(Block, self).__init__()
self.in_channel = in_channel#定义输入通道
self.out_channel = out_channel#定义输出通道
self.last_decoder = last_decoder
# selection matrix 定义一个五行三列的矩阵作为 选择矩阵
alpha = torch.nn.Parameter(torch.ones((5, 3)), requires_grad=True)
torch.nn.init.xavier_uniform_(self.alpha)
def forward(self, x, skip):
bn, c, w, h = x.size()
if skip is not None:#经常用于CNN,因为conv2d的输入必须是四维的(batch,channel,height,width),如果输入的是文本的话通常只是三维的(batch,length,dim),因此需要unsqueeze(1),增加一维channel,才能做卷积操作。
aligned_skip = [F.interpolate(v, size=x.size()[-2:], mode='bilinear').unsqueeze(-1) for v in skip+[x]]#采样的方法采用双线性插值(bilinear)模式,在倒数第二维上增加一个维度
aligned_skip = torch.cat(aligned_skip, dim=-1) # bn c w h 5kernel_size 采样后用与倒数第二维连接
score = F.gumbel_softmax(self.alpha, dim=0)#为了解决不可导的问题,采用Gumbel softmax并对离散样本进行随机采样和实现梯度可导。
skip = torch.matmul(aligned_skip, score) # bn c w h 3 kernel_size 矩阵相乘, 化为完全可微的方程
# weight matrix 权重矩阵
maxidx = torch.argmax(self.alpha, dim=0, keepdim=False)#返回指定维度最大值的序号,dim给定的定义是:the demention to reduce.也就是把dim这个维度的,变成这个维度的最大值的index,同时去掉第一个维度。
un, idx, counts = torch.unique(maxidx, return_inverse=True, return_counts=True, dim=0)#将原始数据中的每个元素在新生成的独立元素张量中的索引输出,返回每个独立元素的个数。类似于数学中的集合,就是挑出tensor中的独立不重复元素。
2.2. Phase2(第二阶段): 渐进式进化搜索确定最佳子结构
(1) 减少阶段一中搜到结构的潜在冗余,引入了一种新颖的进化搜索算法来找到一个进化的跳过子集。
(2) 由于网络依赖从前往后的拓扑顺序, 因此在搜索时需要从最后一对 extraction stage(提取阶段)开始,并逐步移动到第一个。
在传统的进化NAS方法中,最直接的策略是从SuperNet采样不同的子结构(由某些跳跃连接组成),然后分别进行独立的训练。
这种传统策略有两个主要缺陷:
第一,单独使用抽样可能会导致不公平的结果;
第二,从经验上看,搜索过程是缓慢的。假设每个提取阶段的前后需要IF和IB时间,则每一步单独训练所有|P|采样体系结构总共需要2T|P|(IF + IB)。

2.3. 分析搜索的公平性:
为了克服上述第一个缺陷(单独使用抽样可能会导致不公平的结果),本文提出了skip fairness(跳跃公平)的概念,并声称所有连接搜索算法都需要满足这一原则。

上述概念要求,在不同的采样子结构中,任何对应的跳跃连接需要携带相同特征。否则,不一致的特征会影响搜索决策,从而导致不公平结果。由于单独训练采样的子结构产生的传入特征不一致,传统的策略违反了这一原则,因此不直接适用于搜索跳跃链接。

渐进进化搜索概述 (a)第一阶段搜索SuperNet N可以分为头网和尾网 (b)向前和向后传播 ©只保留在P的(帕累托)Pareto前面搜索的跳数
(1) 本文提出的阶段二NAS算法通过共享部分的传入特征来满足跳跃公平。具体来说,假设在第t 和第t+1个提取阶段之间搜索时:从第1个到第t-1个提取阶段的结构是固定的,且可以共享这些阶段的生成特征。这些阶段组成的子结构被称为头网络(图2a)。
(2) 相反,第t到最后一个提取阶段的网络结构随着不同的采样而变化,这种不固定的阶段组成的子结构集被称为尾网络(图2a)。
这些尾网络共享相同的超网络权重,但具有不同的连接方式。
如图2b,头网络生成的特征被传入到所有采样的尾网络中。然后对所有尾网络的loss进行平均,并且仅计算一次梯度。
(3) 在每对提取阶段之间的搜索完成后,如图2c,本文遵循多目标选择标准,该标准基于验证准确性 (IoU) 和计算复杂性 (MACs) 保留在**帕累托(pareto)**前沿的子结构。算法细节和搜索到的BiX-Net详见论文。
帕累托最优解:多目标求解会筛选出一个相对较优的解的集合,在这个集合里就要用到**帕累托(pareto)**找出相对优的解或者最优解。
假设在设计空间中,解A对应的目标函数值优越其他任何解,则称解A为最优解,举个例子,下图的x1就是两个目标函数的最优解,使两个目标函数同时达到最小,但是前面也说过,实际生活中这种解是不可能存在的。真要存在就好了,由此提出了帕累托最优解.

同样假设两个目标函数,对于解A而言,在 变量空间 中找不到其他的解能够优于解A(注意这里的优于一定要两个目标函数值都优于A对应的函数值),那么解A就是帕累托最优解.
举个例子,下图中应该找不到比 x1 对应的目标函数都小的解了吧,即找不到一个解优于 x1 了,同理也找不到比 x2 更优的解了,所以这两个解都是帕累托最优解,实际上,x1-x2 这个范围的解都是帕累托最优解。

帕累托最优前沿:
如下图所示,更好的理解一下帕累托最优解,实心点表示的解都是帕累托最优解,所有的帕累托最优解构成帕累托最优解集,这些解经目标函数映射构成了该问题的帕累托Pareto最优前沿或帕累托Pareto前沿面,即帕累托最优解对应的目标函数值就是帕累托最优前沿。
对于两个目标的问题,其Pareto最优前沿通常是条线。而对于多个目标,其Pareto最优前沿通常是一个超曲面。

#第二阶段
class Phase2(Module):
"""
Phase2 / retraining model of BiX-NAS
"""
def __init__(self,
in_channel: int = 3,
num_classes: int = 1,
iterations: int = 2,
multiplier: float = 1.0,
gene=None,
bionetpp=False,
with_att=False):
super(Phase2, self).__init__()
for iteration in range(self.iterations):
# initialize encoders 定义编码器
for layer in range(self.num_layers):
in_channel = self.filters_list[layer]
out_channel = self.filters_list[layer + 1]
if iteration == 0:
if not enc_skip_or_not[layer]:
conv1 = Conv2d(in_channel, out_channel, kernel_size=(3, 3), padding=(1, 1), stride=(1, 1), bias=False)
conv2 = Conv2d(out_channel, out_channel, kernel_size=(3, 3), padding=(1, 1), stride=(1, 1), bias=False)
else:
conv1 = None
conv2 = None
print('enc', layer, 'abandonned, conv is none!')
block = Block(in_channel, out_channel, (conv1, conv2), self.batch_norm_momentum, gene[count][layer])
self.add_module("iteration{0}_layer{1}_encoder_blocks".format(iteration, layer), block)
self.encoders.append(block)
count += 1
# initialize decoders 定义解码器
for layer in range(self.num_layers):
in_channel = self.filters_list[self.num_layers - layer]
out_channel = self.filters_list[self.num_layers - 1 - layer]
if iteration == 0:
if not dec_skip_or_not[layer]:
conv1 = Conv2d(in_channel, out_channel, kernel_size=(3, 3), padding=(1, 1), stride=(1, 1), bias=False)
conv2 = Conv2d(out_channel, out_channel, kernel_size=(3, 3), padding=(1, 1), stride=(1, 1), bias=False)
else:
conv1 = None
conv2 = None
print('dec', layer, 'abandoned, conv is none!')
block = Block(in_channel, out_channel, (conv1, conv2), self.batch_norm_momentum, gene[count][layer])
self.add_module("iteration{0}_layer{1}_decoder_blocks".format(iteration, layer), block)
self.decoders.append(block)
count += 1
# bridge block 定义桥接模块
self.middles = Sequential(
Conv2d(self.filters_list[-1], self.filters_list[-1], kernel_size=(3, 3), padding=(1, 1), stride=(1, 1), bias=False),
GroupNorm(self.filters_list[-1]//16, self.filters_list[-1]) if NORM_TYPE == 'GN' else BatchNorm2d(self.filters_list[-1], momentum=self.batch_norm_momentum),
ReLU(),
Conv2d(self.filters_list[-1], self.filters_list[-1], kernel_size=(3, 3), padding=(1, 1), stride=(1, 1), bias=False),
GroupNorm(self.filters_list[-1]//16, self.filters_list[-1]) if NORM_TYPE == 'GN' else BatchNorm2d(self.filters_list[-1], momentum=self.batch_norm_momentum),
ReLU()
)
# post processing
self.post_transform_conv_block = Sequential(
Conv2d(self.filters_list[0], self.initial_filter, kernel_size=(3, 3), padding=(1, 1), stride=(1, 1), bias=False),
#ReLU(inplace=True),
#GroupNorm(self.initial_filter//16, self.initial_filter),
BatchNorm2d(self.initial_filter, momentum=self.batch_norm_momentum),
ReLU(inplace=True),
Conv2d(self.initial_filter, self.initial_filter, kernel_size=(3, 3), padding=(1, 1), stride=(1, 1), bias=False),
#ReLU(inplace=True),
#GroupNorm(self.initial_filter//16, self.initial_filter),
BatchNorm2d(self.initial_filter, momentum=self.batch_norm_momentum),
ReLU(inplace=True)
)
def head_forward(self, x, iterations):
"""
forward behavior for head networks 定义向前传播的头网络
"""
enc = [None for i in range(self.num_layers)]
dec = [None for i in range(self.num_layers)]
enc = [x] + enc
x = self.pre_transform_conv_block(x)
e_i = 0
d_i = 0
for iteration in range(iterations):
for layer in range(self.num_layers):
if iteration%2 == 0 and layer == 0:
x_in = x
# encoder 定义编码器
if iteration%2 == 0:
x_in = self.encoders[e_i](x_in, dec if iteration != 0 else [])
enc[layer+1] = x_in
x_in = F.max_pool2d(x_in, 2)
e_i = e_i + 1
# decoder 定义解码器
else:
x_in = self.decoders[d_i](x_in, enc[1:])
dec[layer] = x_in
x_in = F.interpolate(x_in, size=enc[-1 - layer - 1].size()[-2:], mode='bilinear', align_corners=True)
d_i = d_i + 1
if iteration%2 == 0:
x_in = self.middles(x_in)
x_in = F.interpolate(x_in, size=enc[-1].size()[-2:], mode='bilinear', align_corners=True)
return_value= {}
return_value['x'] = x
return_value['x_in'] = x_in
return_value['enc'] = enc
return_value['dec'] = dec
return_value['e_i'] = e_i
return_value['d_i'] = d_i
return return_value
def tail_forward(self, x, iterations, return_value):
"""
forward behavior for tail networks 定义向前传播的尾网络
"""
x = return_value['x']
x_in = return_value['x_in']
enc = return_value['enc']
dec = return_value['dec']
e_i = return_value['e_i']
d_i = return_value['d_i']
for iteration in range(iterations, self.iterations * 2):
for layer in range(self.num_layers):
if iteration%2 == 0 and layer == 0:
x_in = x
# encoder 定义编码器
if iteration%2 == 0:
x_in = self.encoders[e_i](x_in, dec if iteration != 0 else [])
enc[layer+1] = x_in
x_in = F.max_pool2d(x_in, 2)
e_i = e_i + 1
# decoder 定义解码器
else:
x_in = self.decoders[d_i](x_in, enc[1:])
dec[layer] = x_in
x_in = F.interpolate(x_in, size=enc[-1 - layer - 1].size()[-2:], mode='bilinear', align_corners=True)
d_i = d_i + 1
if iteration%2 == 0:
x_in = self.middles(x_in)
x_in = F.interpolate(x_in, size=enc[-1].size()[-2:], mode='bilinear', align_corners=True)
x_in = self.post_transform_conv_block(x_in)
x_in = self.post2(x_in)
return x_in
def search(args):#定义搜索函数
"""
Conduct Phase2 search from the last extraction stage pair to the first 在第二阶段,从最后的提取对搜索到第一个对
:new_networks: networks that ready to be searched, i.e., retained networks from the preceding search iteration 从上一次搜索迭代中保留的网络
:candidate: number of retained networks at each search iteration 在每次搜索迭代中保留的网络数量
"""
# load data first!!
_, _, train_loader, test_loader = load_data(args)
hyper_network = decode(args.gene, args.iter, 4) # Phase1 searched architecture 第一阶段的搜索结构
new_networks = [hyper_network] # retained networks at each generation #每次搜索后留下的网络参数
candidate = [2,2,2,2,2,3] # number of retained networks at each generation每一次提取阶段保留网络的数量
for iteration in range(2*args.iter-1, 0, -1): # 从最后一对提取对搜索到第一对
# sample and search between an extraction stage pair 在每个提取对中进行采样和搜索
new_networks = search_single_iteration(args, hyper_network, new_networks, iteration)
# train
networks, scores = train_single_iteration(args, new_networks, iteration, train_loader, test_loader)
# sort based on iou 在交并比中搜索
#IoU 的全称为交并比(Intersection over Union),通过这个名称我们大概可以猜到 IoU 的计算方法。IoU 计算的是 “预测的边框” 和 “真实的边框” 的交集和并集的比值。
sorted_idx = sorted(range(len(scores)), key=lambda k: scores[k][0])[:candidate[iteration]]
print('Top networks are: ', sorted_idx)
new_networks = [networks[idx] for idx in sorted_idx] # ready to be searched at the next search iteration准备下次提取对的搜索迭代
三、实验结果
MoNuSeg、TNBC和CHAOS三个不同的医学图像数据集进行分割验证。
(1) MoNuSeg数据集包含30张训练图像和14张大小为1000X1000的测试图像,这些图像是从不同器官的整张幻灯片图像中裁剪出来的。
(2) TNBC数据集作为额外的验证数据集,包含从50张不同组织区域的组织病理学图像中获得的512X512个子图像。
(3)对来自CHAOS数据集的MRI扫描进行了5次交叉验证,以评估BiX-Net在腹部器官分割任务中的概化能力。该任务包含了来自T1-DUAL(同相和反相)和T2-SPIR的120个DICOM图像序列,空间分辨率为256X256。通过最小最大归一化和自动对比度增强对原始序列进行预处理。
BiX-Net在nuclei segmentation(核分割)和organ segmentation(器官分割)上都达到了SOTA的准确率,但是仅需0.43M参数量和28G MACs。
可以看见,U-Net的计算量超过BiX-Net将近23倍,BiO-Net的计算量则是超过将近40倍。
细胞核分割:作者的方法与普通U-Net、最先进的循环U-Net变体和同类状态的技术NAS搜索网络进行了比较。所有模型都是从头开始训练的,最终结果报告为三次独立运行的平均值。表1显示,我们的普通BiX-Net的性能明显优于先进的NAS对等物,并且在显著降低网络复杂性的情况下取得了与BiO-Net相当的结果。值得注意的是,我们在TNBC上的结果远高于其他所有人,说明我们的泛化能力较强。所有数据集的定性比较如图3所示。

多器官分割:CHAOS挑战的目标是在CT或MRI上分别精确分割四个腹部器官:肝脏、左肾、右肾和脾脏。我们没有将每个类上的网络训练成几个独立的二值分割任务,而是复制所有模型,直接输出所有类的日志。与核分割相似,从表2可以看出,在最先进的NAS搜索网络中,BiX-Net在所有类中都取得了最好的性能,并且计算复杂度低得多。


此外,通过在核数据集上进行了两项消融研究,直接训练BiO-Net++ 和 Phase1(阶段一)搜索体系结构进行比较。
如表1所示,与BiO-Net++相比,BiX-Net的Phase1(第一阶段)搜索算法减少了8.6%的MACs, BiX-Net最终实现了18.5%的MACs减少,这验证了BiX-NAS的(阶段一)Phase1和(阶段二)Phase2搜索的必要性。
消融研究(ablation experiment):” 术语“消融研究”通常用于神经网络,尤其是相对复杂的神经网络,如R-CNN。我们的想法是通过删除部分网络并研究网络的性能来了解网络。“
在机器学习,特别是复杂的深度神经网络的背景下,已经采用“消融研究”来描述去除网络的某些部分的过程,以便更好地理解网络的行为。

四、结论:
在本文中,提出了一种高效的搜索编码器和解码器之间双向多尺度跳跃连接的两阶段NAS算法,即BiX-NAS。
(1) 新的选择矩阵跟踪可微分NAS以缩小搜索空间。
(2) 提出了一种有效的 渐进式进化搜索 算法。搜索的BiX-Net以 更少的参数和计算成本 超过了其他搜索算法。























 516
516

 被折叠的 条评论
为什么被折叠?
被折叠的 条评论
为什么被折叠?








